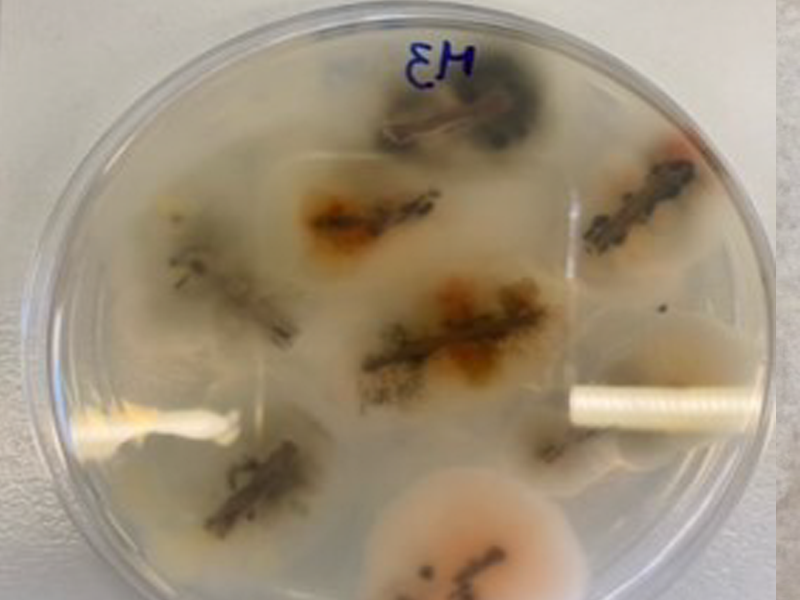
m

fITODIAGNOSIS
FITODIAGNOSIS – Diagnóstico de Doenças e Aconselhamento Técnico de Tratamento de Plantas
A tecnologia FITODIAGNOSIS utiliza técnicas de diagnóstico de doenças em plantas e aconselhamento sobre métodos de controlo preventivos e curativos.
O diagnóstico precoce das doenças de plantas e o reconhecimento dos primeiros sinais e sintomas são cruciais para evitar perdas de produção, ou tratamentos drásticos que ponham em causa o rendimento final de uma cultura.
A otimização de vários métodos de diagnóstico, tais como microbiológicos clássicos, sorológicos e moleculares, permitem-nos ter um vasto leque de tecnologias à disposição de agricultores individuais e empresas agrícolas de modo a permitir um diagnóstico rápido de uma doença ou a previsão do seu aparecimento tendo em conta os modelos de previsão de doença. Conhecendo qual o agente patogénico presente numa planta ou numa cultura e sempre que necessário a sua quantificação podemos desenhar estratégias de tratamento e mitigação desses agentes permitindo qua a cultura produza ao máximo que lhe é permitido pelo seu potencial genético.
Desde há várias décadas que os Laboratórios de Virologia e Vegetal e Micologia do MED/Universidade de Évora têm vindo a fazer a prestação de serviços no apoio ao diagnóstico e aconselhamento técnico para doenças de plantas. Inicialmente com técnicas baseadas em microbiologia clássica e posteriormente com recurso a técnicas moleculares como PCR convencional e quantitativo, sequenciação parcial ou total de genes e mais recentemente com sequenciação de nova geração de modo a diagnosticar não apenas um agente patogénico, mas sim toda a comunidade de microrganismos patogénicos e não patogénicos presentes numa determinada amostra de planta ou solo.
Para além do diagnóstico do/s microrganismo/s causadores de doença disponibilizamos também um serviço de aconselhamento de intervenção baseado em proteção integrada e recorrendo sempre que possível às tecnologias mais sustentáveis para o meio ambiente.
Benefícios
- Permite uma resposta rápida acerca do agente patogénico causador da doença numa planta ou cultura;
- Impede a perda de produção devido à doença pois para além do diagnóstico também há um aconselhamento de tratamento e prevenção baseado em modelos de previsão da doença para os anos seguintes;
- Diminuição dos custos de tratamento devido à deteção rápida e capacidade de deteção precoce utilizando técnicas de elevada sensibilidade.
Galeria de imagens

Galeria de vídeos
Fitodiagnosis - Tecnologia num pitch
Classificação desta tecnologia
A sua classificação é muito importante para nós